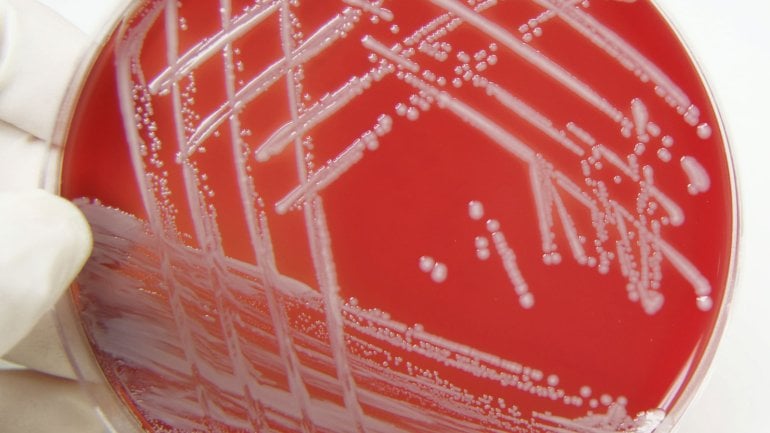

Phlegmone
Eine Phlegmone ist eine meist eitrige, bakterielle Entzündung, die sich in den tieferen Hautschichten (Lederhaut, Fettgewebe der Unterhaut) entlang von Muskeln, Sehnen und Bändern ausbreitet.
Dieser Text entspricht den Vorgaben der ärztlichen Fachliteratur, medizinischen Leitlinien sowie aktuellen Studien und wurde von Mediziner*innen geprüft.
Überblick
Dabei stirbt das betroffene Gewebe ab und verflüssigt sich unter Eiterbildung. Diesen Vorgang nennt man auch Gewebeeinschmelzung. Phlegmone treten häufig an Beinen oder Händen auf – so zum Beispiel in Form der Hohlhandphlegmone, bei der die Entzündung im Bereich der Handfläche liegt.
Phlegmone: Symptome
Anfangs entwickelt sich die Entzündung meist langsam und bereitet keine Beschwerden. Je nach Ausdehnung zeigen sich im weiteren Verlauf einer Phlegmone typische Symptome wie:
- eine flächenhaft bläulich-rote, überwärmte Haut und
- eine schmerzhafte, teigig aussehende Schwellung an der betroffenen Stelle.
Ist die Phlegmone fortgeschritten, treten weitere Beschwerden hinzu wie:
Ursachen für Phlegmone
Eine Phlegmone entsteht oft nach einer – auch kleinen – Verletzung. Bei Personen mit Durchblutungsstörungen wie zum Beispiel Diabetikern können schon minimale Verletzungen als Eintrittspforte für Erreger dienen.
Aber auch nach einer Operation kann es zu einer Phlegmone kommen, wenn Bakterien in das Körperinnere gelangen, etwa durch einen infizierten Katheter. In der Regel handelt es sich dabei um Staphylokokken, seltener sind auch Streptokokken oder andere Bakterienarten (z.B. Clostridien) die Ursache.
Phlegmone: Diagnose
Der Arzt erkennt eine Phlegmone oft bereits anhand der Symptome. Im Blut sind zudem Entzündungszeichen nachweisbar. Um den genauen Erreger zu bestimmen, kann der Arzt eine Gewebeprobe entnehmen.
Phlegmone: Ein Beispiel
In die Arztpraxis kommt ein Patient, der seit einiger Zeit eine kleine Verletzung an der Hand aufweist. Er hatte die betroffene Hautstelle nicht weiter behandelt, sondern lediglich mit einem Pflaster verarztet. Jetzt aber ist die Hand gerötet, heiß, geschwollen und schmerzt. Zudem fühlt sich der Patient in letzter Zeit abgeschlagen und hat Fieber bekommen. Nachdem er dem Arzt berichtet hat und dieser sich die Hand angesehen hat, diagnostiziert der Mediziner: Eine Phlegmone hat sich gebildet.
Behandlung von Phlegmone
Eine Phlegmone muss in jedem Fall behandelt werden, um zu verhindern, dass sie sich weiter ausbreitet. Hochdosierte Antibiotika, die meist durch die Vene verabreicht werden, bekämpfen die Bakterien. Häufig ist eine Operation notwendig. Dabei eröffnet der Chirurg die entzündete Stelle, spült diese mit einer antiseptischen Lösung und leitet den Eiter über eine sogenannte Drainage ab. Anschließend muss der Patient die betroffene Körperpartie ruhigstellen – zum Beispiel mithilfe einer Schiene oder eines Gipsverbands – und wenn möglich hochlagern. Auch antientzündliche, feuchte Umschläge sind hilfreich.
Manche Erkrankungen rufen ähnliche Symptome wie eine Phlegmone hervor, so zum Beispiel eine tiefe Beinvenenthrombose. Auch ist es für den Arzt nicht immer leicht, eine Phlegmone von der sogenannten Wundrose (Erysipel) abzugrenzen – zumal es hier auch Mischformen zwischen beiden Erkrankungen gibt. Ein Erysipel zeichnet sich in der Regel durch eine schärfere Hautbegrenzung und stärkere Rötung aus, kann jedoch in eine Phlegmone übergehen.
Suchen Sie bei Verdacht auf eine Phlegmone den Arzt auf!
Phlegmone: Verlauf
Da die Entzündung nicht – wie etwa bei einem Abszess – abgekapselt ist, dehnt sie sich leicht auf umliegendes Gewebe aus. Bleibt die Phlegmone unbehandelt, können bleibende Schäden an Nerven und Gefäßen die Folge sein. Hat sich die Entzündung auf dem Blutweg in den gesamten Körper ausgebreitet, kann sich eine Blutvergiftung entwickeln. In diesem Fall ist eine umgehende Therapie mit Antibiotika erforderlich, da ansonsten eine lebensbedrohliche Situation entstehen kann.
Um solche Komplikationen zu vermeiden, sollten Sie bei möglichen Anzeichen einer Phlegmone sicherheitshalber den Arzt kontaktieren.